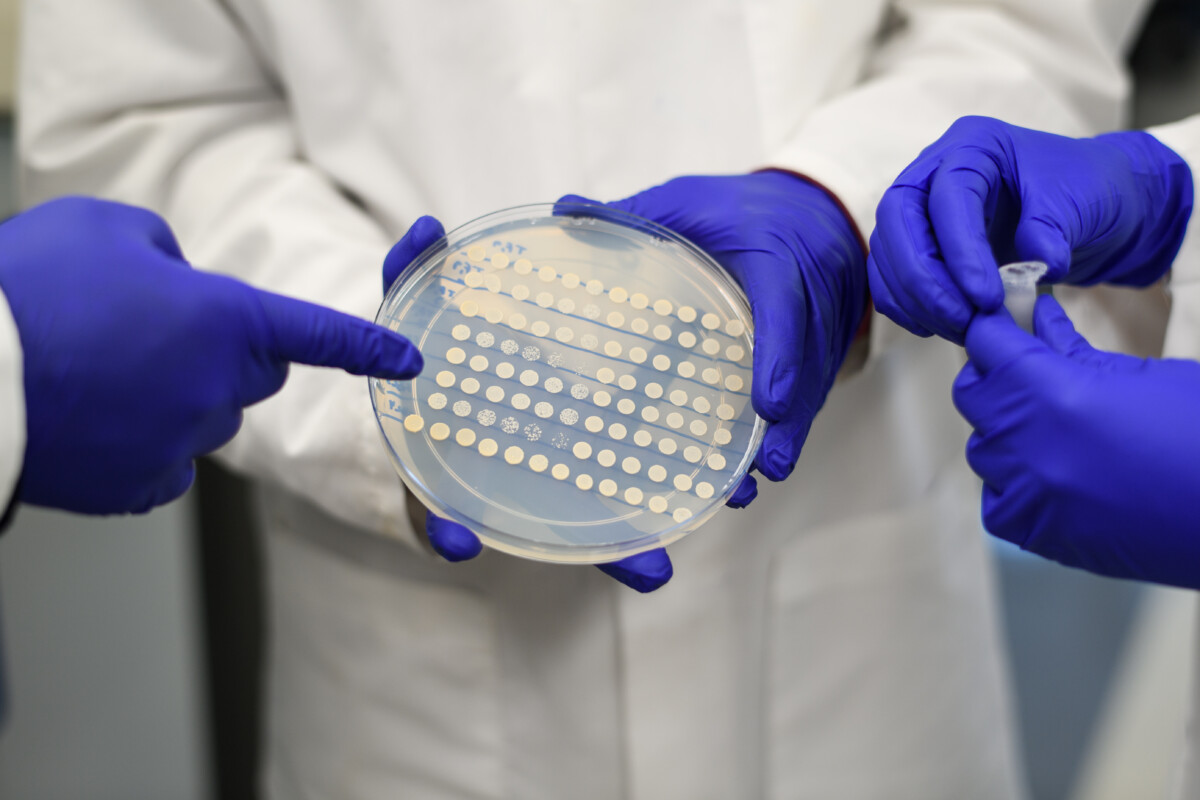
Photos by Sameer A. Khan/Fotobuddy

Welcome to the Avalos group! Our mission is to engineer microbes with new desirable traits to address challenging problems in sustainable energy, human health, sustainable manufacturing, and the environment.
Our research interests span metabolic engineering, subcellular engineering (including organelle and mitochondrial engineering), synthetic biology (including biosensors, optogenetics, and genetic circuits), systems biology, structural biology, and protein engineering. We take a two-pronged approach to our research. On one hand, we engineer cells forging established methods with new technologies developed in the lab. On the other, we address fundamental questions of protein structure and function, cellular physiology, and metabolism that either currently limit our capabilities in cellular engineering, or that offer opportunities for new technologies. These two facets of the lab complement and fuel each other, as technological developments give rise to new fundamental questions, and basic research opens avenues for new technologies.
We are part of the Andlinger Center for Energy and the Environment and the Department of Chemical and Biological Engineering, and we are associated with the Department of Molecular Biology.
Latest News
- Saurabh’s paper on the optoPlateReader available on bioRxiv!
- Shannon and Allison publish review on optogenetics in microbial engineering!
- Avalos lab welcomes new graduate students!
- Shannon wins ExxonMobil award for best graduate student poster at Andlinger annual retreat!
- José Avalos Promoted to Associate Professor!